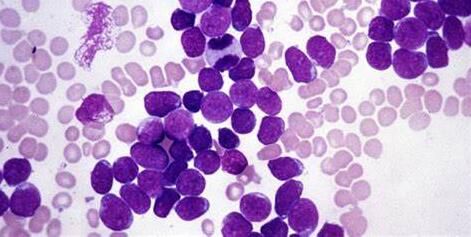
技术资料图片1

MLL重排白血病(MLL-r leukaemias)一种白血病亚型,其拥有特殊的遗传结构-MLL重排结构,这种疾病发生在大约80%的急性白血病婴儿(1岁以下)和10%的所有白血病患者中,包括急性淋巴细胞白血病(ALL)和急性髓性白血病(AML),由于会对化疗耐受且难以治疗,MLL-r白血病往往会引发很多患者死亡,而那些幸存下来的患者由于接受了较高强度的治疗,往往会对其机体健康产生长期的影响。
近日,一项刊登在国际杂志Cancer Cell上的研究报告中,来自澳大利亚和美国的科学家们通过研究研究开发出了一种新方法来治疗某些严重的白血病,包括影响婴儿健康的恶性白血病等。
这项研究中,研究人员开发了一种针对MLL-r白血病的新型疗法,该疗法具有出色的药物特性,当用来治疗出生就患有MLL-r白血病(来自人类患者)的小鼠时,这种疗法能够产生一种明显的反应,从而治疗很多患病小鼠。研究人员希望这种新型疗法能够治疗MLL-r白血病人类患者,同时他们也希望这种疗法能够迅速进入临床试验阶段。
目前在治疗MLL-r白血病上我们迫切需要开发新的治疗方法,当前使用的组合性药物疗法并不时非常有效,且会给患者带来严重的副作用,这对于任何人而言都是不可取的,对于儿童尤其如此,因为其正在发育的机体非常容易受到有毒药物的影响。
研究者新开发的这种小分子抑制剂名为VTP50469,其是一种新型的靶向性疗法,能够特异性地靶向作用对癌细胞生长和生存至关重要的分子,这类疗法在治疗效率上要优于当前常规的药物疗法,且其引发的副作用较小;以MLL-r白血病为例,这种药物分子的靶点就是Menin和MLL融合蛋白,这两种蛋白 在白血病细胞中能相互作用来驱动细胞的生长。
当单独使用VTP50469时,其能表现出显著的抗白血病效应,后期研究人员还会进行更为深入的研究来证实该药物的确在人类患者机体中能发挥相应的药效。